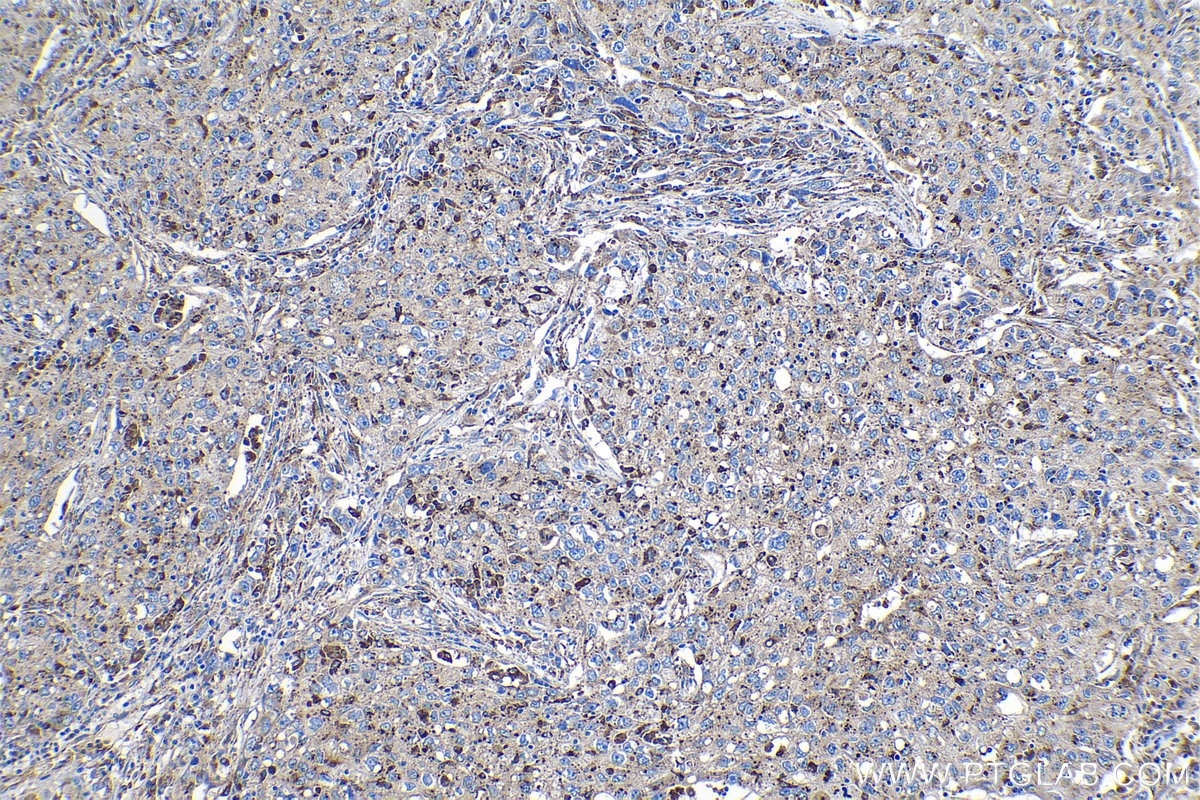

IHCeasy® GRN Ready-To-Use IHC Kit
GRN Ready-to-use reagent kit for IHC.
Reactivity
Human
Sample Type
FFPE tissue
Cat no : KHC1132
Synonyms
acrogranin, GEP, GP88, granulin, Granulin A Granulin 5, Granulin B Granulin 4, Granulin C Granulin 6, Granulin D Granulin 7, Granulin E, Granulin F Granulin 3, Granulin G Granulin 2, Granulins, GRN, PCDGF, PEPI, PGRN, Proepithelin
Validation Data Gallery
Product Information
KHC1132 is a ready-to-use IHC kit for staining of GRN. The kit provides all reagents, from antigen retrieval to cover slip mounting, that require little to no diluting or handling prior to use. Simply apply the reagents to your sample slide according to the protocol and you're steps away from obtaining high-quality IHC data.
| Product name | IHCeasy GRN Ready-To-Use IHC Kit |
| Sample type | FFPE tissue |
| Assay type | Immunohistochemistry |
| Primary antibody type | Rabbit Polyclonal |
| Secondary antibody type | Polymer-HRP-Goat anti-Rabbit |
| Reactivity | Human |
Kit components
| Component | Size | Concentration |
|---|---|---|
| Antigen Retrieval Buffer | 100 mL | 50× |
| Washing Buffer | 100 mL ×2 | 20× |
| Blocking Buffer | 5 mL | RTU |
| Primary Antibody | 5 mL | RTU |
| Secondary Antibody | 5 mL | RTU |
| Chromogen Component A | 0.2 mL | RTU |
| Chromogen Component B | 4 mL | RTU |
| Signal Enhancer | 5 mL | RTU |
| Counter Staining Reagent | 5 mL | RTU |
| Mounting Media | 5 mL | RTU |
| Datasheet | 1 Copy | |
| Manual | 1 Copy |
Background Information
GRN, also known as PGRN or PCDGF, is a cysteine-rich protein. PGRN is a unique growth factor that plays an important role in cutaneous wound healing. It has an anti-inflammatory effect and promotes cell proliferation. When PCDGF is degraded to several 6-25 kDa fragments, called granulins (GRNs) by neutrophil proteases, a pro-inflammatory reaction occurs. PGRN is widely expressed, particularly in epithelial cells, immune cells, neurons, and chondrocytes. High levels of PGRN expression have been reported in human cancers, and its expression is closely correlated with the development and metastasis of several cancers. The recent discovery that mutations in the gene encoding for pro-granulin (GRN) cause frontotemporal lobar degeneration (FTLD), and other neurodegenerative diseases leading to dementia, has brought renewed interest in progranulin and its functions in the central nervous system.
Properties
| Storage Instructions | All the reagents are stored at 2-8°C. The kit is stable for 6 months from the date of receipt. |
| Synonyms | acrogranin, GEP, GP88, granulin, Granulin A Granulin 5, Granulin B Granulin 4, Granulin C Granulin 6, Granulin D Granulin 7, Granulin E, Granulin F Granulin 3, Granulin G Granulin 2, Granulins, GRN, PCDGF, PEPI, PGRN, Proepithelin |